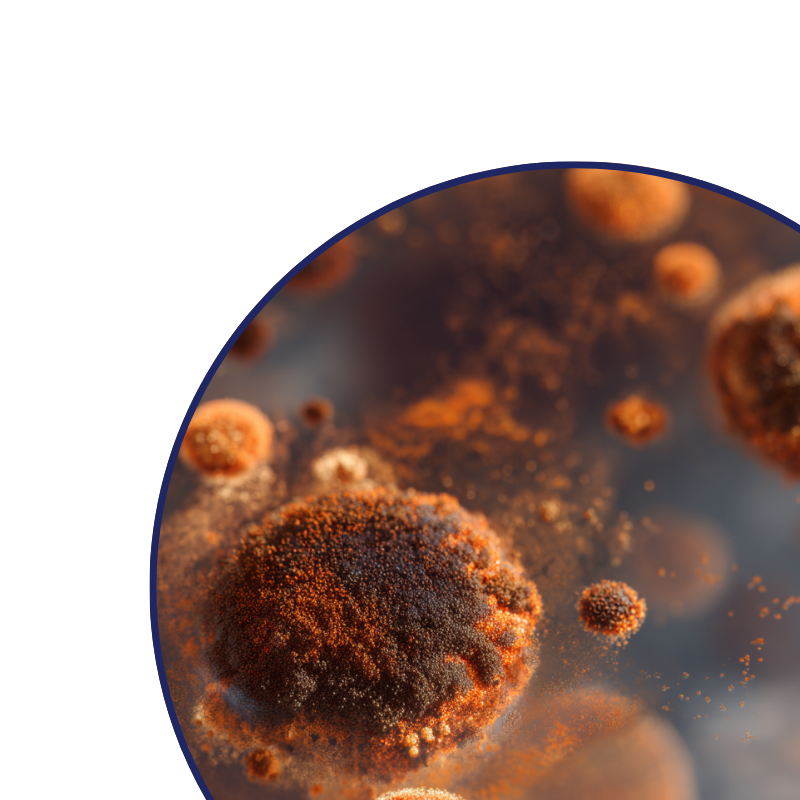

I’ve struggled with stubborn acne for years and always blamed my skincare routine. I never realised my shower water was part of the problem. Since using the filter, my breakouts have reduced so much and my skin finally feels calmer and clearer after every shower. I wish I had switched sooner.








The PuraHome™ Rainfall Shower Filter sets a new standard for family wellness. Built with advanced multi-layer NanoFiltration, it reduces over 90% of chlorine, chloramine, heavy metals, fluoride, VOCs, bacteria, and microplastics — the very contaminants linked to eczema, dandruff, dry skin, and hair damage.
Unlike ordinary filters, it doesn’t just remove what’s harmful — it helps maintain a natural balance by preserving healthy minerals. The result? Softer skin, stronger hair, and relief from irritation with every shower.
Because at PuraHome™, we believe clean water is the foundation of a healthier, happier family.
No plumber needed. No complicated setup. Just twist it on.
- Compatible with most standard taps
- Installs in less than 60 seconds
We’ve made it foolproof — because protecting your home should be that easy.
Shipping
- Free shipping on all orders — no minimum spend
- All deliveries are fully trackable via Australia Post
Returns & Guarantee
- 30-night risk-free trial — not satisfied? Return it for a full refund
- Free returns — we cover the cost, no questions asked
- If anything breaks, leaks, or doesn’t fit — we’ll replace it or send out free parts
We're here to make it right, every step of the way.
- FREE Shipping — always on every order.
- FREE Welcome Kit — with your first subscription delivery (2 Free filters + 5 adapters + welcome note).
- Locked-In Protection — never run out, never worry about stock shortages.
- Cancel Anytime — no contracts, full control at your fingertips.
- Priority Family Safety — your home is always first in line for fresh filters.
Refills ship every 3 months automatically. You’ll get a reminder before each shipment, and you can skip, pause, or cancel anytime with one click.
PuraHome™ - RainFall Filtered Shower Head
As low as $41.24/month with
What You Can’t See… Might Be Hurting Your Family.
Our Premium Shower filter removes up to 90% of damaging chlorine, heavy metals, and other harmful chemicals, enriched with Vitamin C for healthier, softer skin and shinier hair.
All while saving 25% of your water to reduce your bills.
Instantly Removes 150+ damaging Threats
Softer Hair. Calmer Skin.
Microbiome & Eczema Safe
This product has limited availability.
72% already subscribed
Just pay for your Filter
-
Just $19.99/month for fresh, clean water
-
$131.99 today, then only $59.99 every 3 months (per filter)
-
Free shipping every delivery
-
Filters refreshed every 3 months
-
Pause, skip, or cancel anytime
1 Filter cartridges delivered every:
Estimate delivery between
30 Day-Risk free-money back guanrantee
* Free shipping applies to every order
Adjust order intervals, skip orders, or pause. Cancel anytime.
Auto-Renewal Terms Discount codes not applicable to subscriptions unless otherwise specified.
- What’s included inside
- Extra Bonuses

PuraHome Base Unit

1 FREE Cartridge

FREE Shipping

Effortless Refill Every 3 Months
FREE Shipping
FREE Shipping Insurance
FREE Returns
FREE Weekly Giveaway Entry
30-Night Risk Free Trial
Priority Customer Support
The PuraHome™ Rainfall Shower Filter sets a new standard for family wellness. Built with advanced multi-layer NanoFiltration, it reduces over 90% of chlorine, chloramine, heavy metals, fluoride, VOCs, bacteria, and microplastics — the very contaminants linked to eczema, dandruff, dry skin, and hair damage.
Unlike ordinary filters, it doesn’t just remove what’s harmful — it helps maintain a natural balance by preserving healthy minerals. The result? Softer skin, stronger hair, and relief from irritation with every shower.
Because at PuraHome™, we believe clean water is the foundation of a healthier, happier family.
No plumber needed. No complicated setup. Just twist it on.
- Compatible with most standard taps
- Installs in less than 60 seconds
We’ve made it foolproof — because protecting your home should be that easy.
Shipping
- Free shipping on all orders — no minimum spend
- All deliveries are fully trackable via Australia Post
Returns & Guarantee
- 30-night risk-free trial — not satisfied? Return it for a full refund
- Free returns — we cover the cost, no questions asked
- If anything breaks, leaks, or doesn’t fit — we’ll replace it or send out free parts
We're here to make it right, every step of the way.
- FREE Shipping — always on every order.
- FREE Welcome Kit — with your first subscription delivery (2 Free filters + 5 adapters + welcome note).
- Locked-In Protection — never run out, never worry about stock shortages.
- Cancel Anytime — no contracts, full control at your fingertips.
- Priority Family Safety — your home is always first in line for fresh filters.
Refills ship every 3 months automatically. You’ll get a reminder before each shipment, and you can skip, pause, or cancel anytime with one click.

*Results Based on a 6-Week Randomized, Controlled, Clinical Trial ¹
92%
noticed a reduction in dry skin after 6 weeks*Results Based on a 6-Week Randomized, Controlled, Clinical Trial ¹
75%
noticed a reduction in acne after 6 weeks83%
of people experienced less hair shedding¹ Our multi-stage filters—including stainless steel mesh, ceramic media, activated carbon, and PP cotton—are manufactured under certified quality controls and tested to international benchmarks.
Results
*Results Based on a 6-Week Randomized, Controlled, Clinical Trial ¹


Eczema
6 weeks
Before
After


Acne
6 weeks
Before
After


Psoriasis
6 weeks
Before
After
Why Filter Your Shower?
How does tap water affect my skin?

Chlorine & Chloramine
Eczema, Psoriasis, Hives, Acne,
Contact Dermatitis & Many More
Center for Disease Control. CDC
Dirt & Rust
Acne, Contact Dermatitis, Rashes,
Skin Infections & Many More
Environmental Working Group. EWG

Germs & Bacteria
Folliculitis, Impetigo, Rashes
& Many More
Center for Disease Control. CDC

Microplastics
Weakened Hair, Dry & Flaky Scalp,
Eczema Flare-Ups & Mnay More
World Heath Organization. WHO

Clean Water. Clear Benefits

Soothe Sensitive Skin
Reduces Irritants That Trigger Skin Conditions
Cuts chlorine, heavy metals, and harsh chemicals that worsen eczema, hives, and rashes — giving your family’s skin the gentle protection it deserves.

Relieve Itchiness
Reduces Drying Agents That Cause Itchy Skin
Filters out chlorine and hard water minerals so every shower leaves skin feeling soft, comfortable, and itch-free.

Gentle for Kids
Reduces Harsh Chemicals That Irritate Children’s Skin
Children’s skin is extra sensitive due to still developing — our filter removes contaminants so bath and shower time is safer, gentler, and worry-free.

Healthier Hair
Reduces Chemical Build-Up That Damages Hair & Scalp
Protects your scalp from chlorine and metals that strip natural oils — leaving hair stronger, shinier, and easier to manage.

Clearer Skin
Reduces Chlorine & Chemicals That Clog Pores
Prevents breakouts and irritation caused by harsh water, helping your family enjoy clearer, healthier complexions.

Scalp & Dandruff Relief
Reduces Contaminants That Dry Out the Scalp
Soothes irritation and flakiness by filtering out chemicals that strip away moisture, calming dandruff and itchiness.

Chemical Protection
Reduces Exposure to Hidden Chemicals in Tap Water
Minimises contact with chlorine, heavy metals, and other contaminants — everyday protection for the whole household.

Family Peace of Mind
Reduces Unseen Risks in Daily Showering
A simple switch that filters what you can’t see, giving you confidence your family is showering in cleaner, safer water.
Top Health Experts Agree
The water you shower in NEEDS filtering


“The evidence is clear. There are 80,000 unstudied & unregulated chemicals in our tap water. These chemicals absorb quickly, readily and completely into our skin. Causing all sorts of health issues.”
J Howard
Know more“Did you know showering for 10 minutes in tap water is like drinking 8 glasses or chlorinated tap water”
DR. DANIEL POMPA
Know moreSee the impact in just 6 weeks
noticed a reduction in dry skin after 6 weeks
noticed a reduction in acne after 6 weeks
of people experienced less hair shedding
felt more confident within their body
Frequently Asked Questions
Will it fit my shower?
Yes if your shower uses a standard ½-inch thread (which is the standard for most international showers). If your existing head screws off by hand or with a wrench, this will screw on in its place.
Is installation complicated?
It’s a simple swap: unscrew your old head, seat the included washer/O-ring, and hand-tighten the PuraHome head until snug. Turn water on to check, then give a small extra turn if needed. No plumber or tools required for most homes.
What does the shower filter reduce?
The cartridge is tuned for chlorine/chloramine (smell & dryness), rust and sediment from pipes, and limescale particles, along with odour-causing organic compounds. The result is shower water that smells cleaner and feels gentler on skin and hair. (Effectiveness varies with local water quality and usage.)
Will it lower my water pressure?
It’s engineered for a strong, comfortable flow. If flow ever feels low, first descale the faceplate nozzles and confirm the washer is seated correctly; if it persists, the cartridge likely needs replacing.
How long do cartridges last, and how will I know it’s time to replace?
Each cartridge lasts about 90 days, depending on household size and water quality. Signs to replace include chlorine smell returning, water feeling harsher, or the filter media darkening. Swapping takes minutes, so keeping a spare ensures no interruptions.
What benefits will I notice?
Showers feel cleaner and fresher with less chlorine smell, leaving skin more comfortable and hair less dry or frizzy. Many people also notice the bathroom air feels lighter because there’s less chlorine vapour in steam.
What’s inside the filter, and is it safe for hot water?
Each cartridge has multiple stages: a sediment trap, a chlorine-reduction layer, and a polishing stage to improve smell and feel. The chrome-finish housing is durable and made for daily hot-water use.
What if it leaks, doesn’t fit, or I change my mind?
If your setup needs an adapter, we’ll advise the right part. And if it still isn’t a match, you’re protected by our 30-day money-back guarantee.